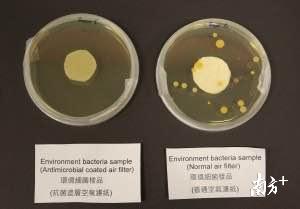
永定河生态建设须防非生态化

“我国许多地方曾经出现过误解生态建设的现象,缺水地区盲目植树造林,用植被建设简单地代替生态建设,植树种草单一化,不注重生态系统结构的优化与生态系统服务功能的恢复,结果造成景观单一、物种单一,不仅没有达到生态建设的目的,甚至造成了对生态环境的进一步破坏。此外,目前规划中以及项目施工中采用的河道衬砌方式和防渗措施,阻止了水系的自然交换,形成了若干人造水泥池,从而阻止水的下渗,破坏了地下水的补充。”这是九三学社北AG九游会官方平台京市委在关于永定河生态发展报告中提出的观点,并在北京市两会召开时,提交给了北京市政协。
九三学社北京市委调查发现,永定河的主要水源官厅水库的AG九游会官方平台入境水量,近年来水量严重衰减,实测平均来水量已由上世纪50年代的19亿立方米减至近几年的2亿多立方米,特别是北京城市社会和经济的持续发展,使水资源紧缺问题愈加突出。在这种情况下,要治理好永定河及北京河流水系,务必解决好水资源的供需矛盾,作好水资源供需平衡分析,实行北京市水资源的统一调度。
同时,有资料表明,永定河山峡地区年排入污水500多万立方米,已成为不可忽视的污染源。以中水为主的水源补给,也可能会因为水质问题而影响流域内植被、鱼类生物等的健康生长,难以确保河流生态系统的健康。如果只考虑水资源利用而不考虑水环境质量和水沙运移规律,特别是目前规划中的以点状湖泊建设为先导的河流恢复措施,很容易因为水流缓慢造成河流型变为湖库型,造成库区泥沙淤积严重和水环境自净能力下降,甚至出现“死湖”现象。
此外,位于北京西南区域的丰台、石景山、大兴、房山、门头沟5区,共处于“北京西部生态建设带”和永定河流域文化带上,地缘相邻,文脉相通,经济互补性强,合作前景广阔,但在发展规划上反映出强烈的“趋同”现象。特别是永定河生态发展带建设,可望使流域生态景观和生态环境发生巨大变化,可能触发房地产市场进一步跃升的趋势。
九三学社北京市委建议,永定河流域生态建设,首要的是生态环境的改善,构建合理的生态系统结构,强化流域生态系统服务功能;须进行生态需水的核算,探索水资源有限情况下生态建设的技术措施;注重流域综合管理,建立生态建设补偿机制。
与此同时,北京市应始终把节约用水放在首位,强化节约用水意识;最大限度地减少水资源浪费,加强部门间协作、联动,编制水源、供水、用水、节水、排水、治污、中水回用、防洪、抗旱、水土保持、生态环境等涉水事务精细管理办法,实现水资源一体化管理和综合管理;加强人工湿地建设,利用湿地生态系统中的物理、化学、生物三重协同作用,通过过滤、吸附、共沉、离子交换、植物吸收和微生物分解,来实现对污水的高效净化,加强水源涵养林保护与建设,加强流域水土保持,实施流域综合管理。
在永定河流域的文化资源挖掘、保护与传承方面,应着眼区域整体品牌提升,构建生态旅游业协作体系;突破行政区域限制,建立协作平台,完善旅游协作机制,推广区域统筹的旅游精品线路,推进区域旅游精品互联互动,提升旅游产业竞争力,共同开发旅游客源,打造旅游品牌,推动永定河流域旅游业协作发展。
只有实施“差异化”发展战略,各区域方能实现共赢,才能最终把永定河建成一条“有水的河、生态的河、安全的河”,成为北京西、南部的绿色生态走廊和生态安全屏障。
- 2026/03/02永定河生态建设须防非生态化
- 2026/03/022026哪种除甲醛产品与方法最靠谱?通风
- 2026/03/02宠物空气净化器哪个牌子好用?十大品牌精选
- 2026/03/02“太空蝴蝶”破蛹展翅我国太空生物试验取得
- 2026/03/02因地制宜、精准施策以高质量污水治理助力美



 客服一
客服一